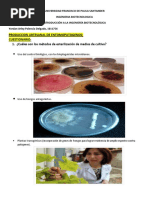

100% encontró este documento útil (1 voto)
210 vistas3 páginasDiptongo y Hiato
El documento presenta una serie de ejercicios sobre diptongos e hiatos en palabras en español. Se pide subrayar los diptongos y agregar tildes a palabras donde corresponda, identificar diptongos y hiatos en un texto dado, y completar una tabla con palabras que contengan diferentes combinaciones vocálicas.
Cargado por
YORDAN PALENCIADerechos de autor
© © All Rights Reserved
Nos tomamos en serio los derechos de los contenidos. Si sospechas que se trata de tu contenido, reclámalo aquí.
Formatos disponibles
Descarga como DOCX, PDF, TXT o lee en línea desde Scribd
100% encontró este documento útil (1 voto)
210 vistas3 páginasDiptongo y Hiato
El documento presenta una serie de ejercicios sobre diptongos e hiatos en palabras en español. Se pide subrayar los diptongos y agregar tildes a palabras donde corresponda, identificar diptongos y hiatos en un texto dado, y completar una tabla con palabras que contengan diferentes combinaciones vocálicas.
Cargado por
YORDAN PALENCIADerechos de autor
© © All Rights Reserved
Nos tomamos en serio los derechos de los contenidos. Si sospechas que se trata de tu contenido, reclámalo aquí.
Formatos disponibles
Descarga como DOCX, PDF, TXT o lee en línea desde Scribd